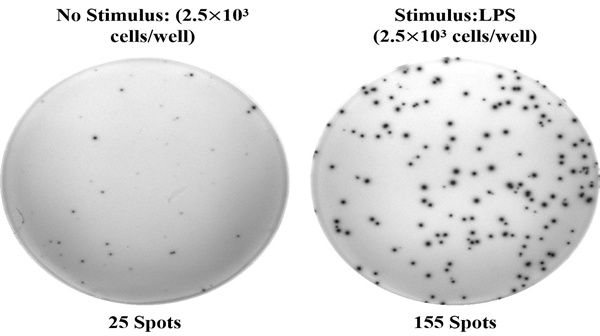
新闻图片1

Elabscience 人IL-6(白介素6)ELISPOT试剂盒:单细胞水平捕捉免疫应答的 “金标准” 工具
253 人阅读发布时间:2025-07-08 15:24
Elabscience® 自主研发的人白介素 6(IL-6)酶联免疫斑点检测试剂盒(货号:ESP-H0009),凭借百万分之一的超高灵敏度,实现单细胞水平的 IL-6 分泌细胞频率检测,为免疫功能研究提供直观、可信的实验数据。无论是基础科研还是临床前研究,都能精准捕捉细胞因子分泌动态,助力解析免疫应答机制。
- 核心功能:专为检测分泌人 IL-6 的细胞频率设计,聚焦细胞因子检测领域,支持单细胞水平的动态免疫功能性分析。
- 规格与价格:提供 96T(¥3000.00)和 96T×5(¥12500.00)两种规格,满足不同实验规模需求。
- 基本参数:
- 反应时间:3 小时 30 分钟
- 样本类型:悬浮细胞
- 样本体积:100μL
- 反应性:仅针对 Human(人源样本)
- 储存条件:2-8℃冷藏保存,有效期 12 个月
人IL-6(白介素6)ELISPOT试剂盒是基于双抗夹心法原理,用抗人IL-6抗体包被于微孔板底部PVDF膜上,实验时加入细胞悬液和刺激剂,细胞在培养过程中分泌的人IL-6会与包被抗体结合。通过洗涤除去细胞和未结合的物质,依次加入生物素化的抗人IL-6抗体和碱性磷酸酶标记的亲和素。生物素化的抗人IL-6抗体与结合在包被抗体上的人IL-6结合、生物素与亲和素特异性结合而形成免疫复合物,游离的成分被洗去。加入显色底物(BCIP/NBT),BCIP在碱性磷酸酶的催化下水解并与NBT发生反应,形成不溶性的深蓝色至蓝紫色斑点。用专业的ELISPOT读板仪软件分析,计算分泌人IL-6的细胞频率。
- 免疫细胞功能研究:如 T 细胞、巨噬细胞等分泌 IL-6 的活性分析;
- 炎症机制探索:IL-6 作为关键炎症因子,其分泌细胞频率与炎症程度关联研究;
- 疫苗研发评价:通过检测免疫后 IL-6 分泌细胞变化,评估疫苗诱导的免疫应答强度;
- 疾病标志物筛选:在自身免疫病、肿瘤微环境等研究中,分析 IL-6 分泌细胞的临床意义。
- 超高灵敏度:达到百万分之一的检测精度,即使极低频率的分泌细胞也能被捕捉(如无刺激时 2.5×10³ 细胞 / 孔仅 25 个斑点,LPS 刺激后增至 155 个斑点,差异显著);
- 单细胞水平解析:直接对应单个分泌细胞,避免传统 ELISA 对群体细胞分泌的 “平均化” 干扰,反映细胞异质性;
- 结果直观可信:斑点清晰可辨,结合专业软件分析,数据重复性高(板内、板间变异系数均 < 10%);
- 操作便捷高效:3.5 小时即可完成检测流程,无需复杂前处理,适合高通量实验设计。
Elabscience® 人 IL-6 ELISPOT 试剂盒凭借超敏检测能力、单细胞水平解析、结果稳定可靠三大核心优势,为免疫功能研究提供精准助力。无论是基础科研中细胞因子分泌机制的深度探索,还是疫苗研发中免疫应答强度的评估,亦或是炎症相关细胞活性的分析,都能凭借百万分之一的超高灵敏度和直观的斑点结果,捕捉每一个分泌细胞的细微动态。